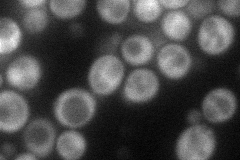
YHL010C
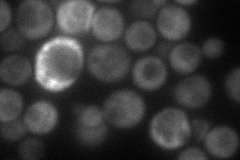
YHL010C
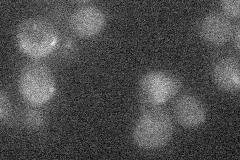
YHL010C
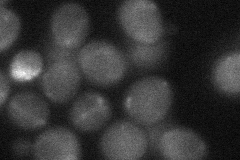
YHL010C
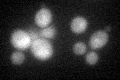
YHL010C
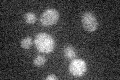
YHL010C

View description
Putative protein of unknown function that is required for growth on ethanol; contains a zinc finger region and has homology to human BRAP2, which is a cytoplasmic protein that binds nuclear localization sequences
Localization:
Intensity:
Fold change:
Significance:
-
C’ GFP library in SD

cytosol19.1 -
N' NOP1pr-GFP in SD
cytosol67.9449 -
N' TEF2pr-mCherry in SD
cytosol53.1869 -
N' NATIVEpr-GFP in SD
below threshold19.1104 -
N' TEF2pr-VC and Cyto-VN in SD
cytosol31.0354 -
C’ GFP library in SD+DTT
cytosol19.951.04No -
C’ GFP library in SD+H2O2

cytosol22.641.18No -
C’ GFP library in Starvation Media
cytosol17.870.93No -
C’ GFP library on the background of Pup2-DaMP

cytosol -
C’ GFP library on the background of CCT mutant

cytosol22.32251.1684No
